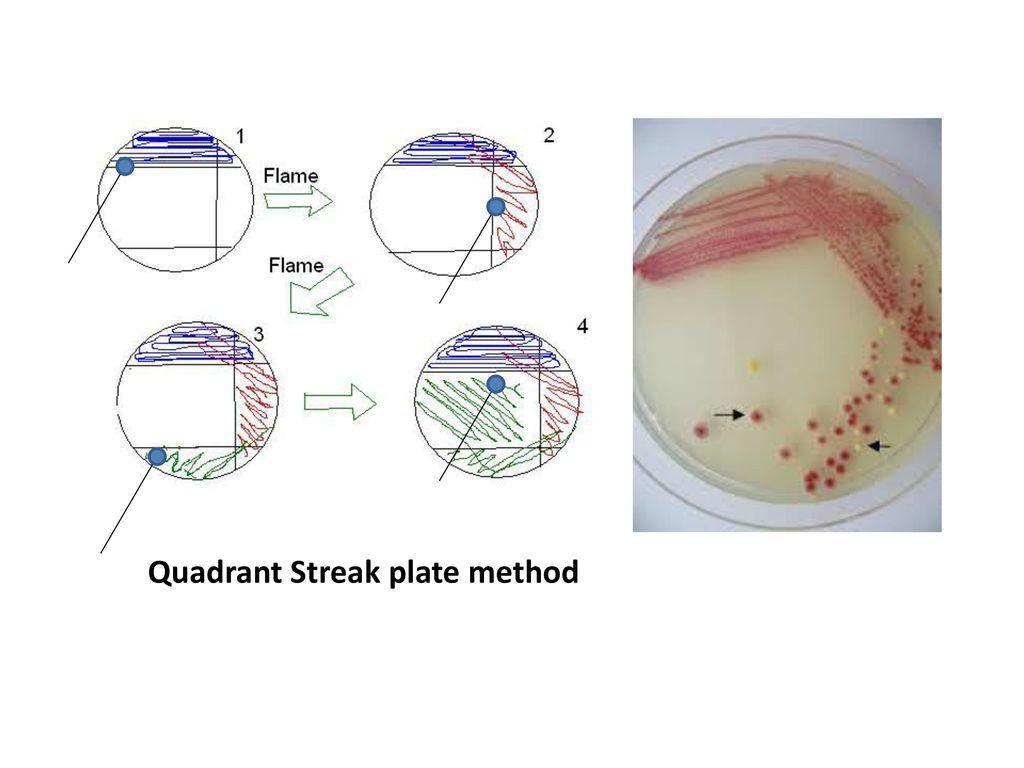
i have attached file 1

i have attached file
2420-Lab 6- Pure Culture, Bacterial Enumeration
Directions:Answer following questions after reading the information and watching the video from the link below. Use color RED for your answers. Submit the completed document on eCampus for grading. Refer to
Pure culture Techniques
Link: Cultivation of Bacteria-Streak plate, Virtual Edge Experiment-3A
This document has 14 questions to answer.
Students MUST use scientific terminology while answering all questions
For each wrong answer 0.5 points will be deducted
Read the information from textbook from chapter 4 review sections 4.3 (pages 96-97)) to answer the following questions.
Pure CultureWhat is a pure culture?
What is the need for a pure culture of bacteria?
How many bacteria are required to start a colony?
Links: Triple streak, Quadrant Streak
What is the purpose of sterilizing the loop in between streaks in this method?
Is this method useful for quantifying bacterial cells in the original culture? Yes Or No- explain your answer:
Study the picture below: Which step showed isolated colonies and why?
The picture from question number 6 shows 3 types bacterial species appearing on red, white and yellow colonies. What does this tell you about the original culture?
Both these methods are “quantitative” meaning you can find out how many bacterial cells you are working with.
Watch this video as well: Serial Dilution
Results: Notice how colonies are counted, why are some colonies embedded in the agar in the pour plate method.
Link: Enumeration of Bacteria, Virtual Edge Experiment-7B and the textbook chapter 4 (sections 4.5 and 4.6) (Nester- McGraw Hill) to answer the following questions:
The video in the above link shows “Spread Plate” technique which makes used of agar plates to spread the diluted samples.
In the Pour Plate technique, liquefied agar cooled to 45-50oC is used instead of a ready agar plate.
What is the difference in the spread plate and pour plate method?
Which of the two methods, spread plate and pour plate has better separation of bacterial colonies?
Why is it necessary to cool down agar to 45-50oC?
Give two scenarios where the number of bacterial cells may be important.
What is CFU?

One ml of a bacterial culture was pipetted into a 9 ml dilution blank. One-tenth ml of this dilution was pipetted into a 9.9 ml dilution blank. From this dilution, one-tenth ml was plated with 25 ml of culture medium. 220 colonies arose after incubation. How many colony-forming units were present per ml of the original culture?

Formula-1: dilution made X amount inoculated = "plated dilution"
1/10 X 1/100 X 1/10 = 1/10,000 or 10–4
Formula-2: dilution factor X number of colonies = number of CFUs/ml
104 X 220 = 2.2 X 106
As we understand the so-called "plated dilution" to represent the actual amount of undiluted sample being tested, we can look at the problem (and similar problems) like this: If 220 colonies arose from plating (the equivalent of) 10–4 ml of the culture, then (proportionally) there would have been 220 X 104 which is same as 2.2 X 106 CFUs per one ml of the original, undiluted culture. This is the reasoning behind the second of the two dilution formulas.
The dilution factor is the inverse of the plated dilution and is meant to inflate the colony count to give the number of CFUs that were in one ml of the original, undiluted sample at the time it was plated out.
Now solve problems 13-14Ten ml of spring water were added to a petri dish to which 40 ml of melted Plate Count Agar were added. After incubation, 35 colonies arose on the plate. What was the count of CFUs per ml of the spring water? (Give the actual CFU, not the dilution factor)
You have obtained a pond water sample and wish to determine the concentration of bacteria which are gram-negative and lactose-fermenting. After making two 1/100 dilutions, you plate 0.1 ml of the second dilution onto each of two plates of MacConkey Agar. After appropriate incubation, you find that one plate contains 155 red colonies and 45 white colonies, and the other plate contains 160 red colonies and 35 white colonies. What was the concentration of gram-negative, lactose-fermenting CFUs per ml of the pond water sample?



